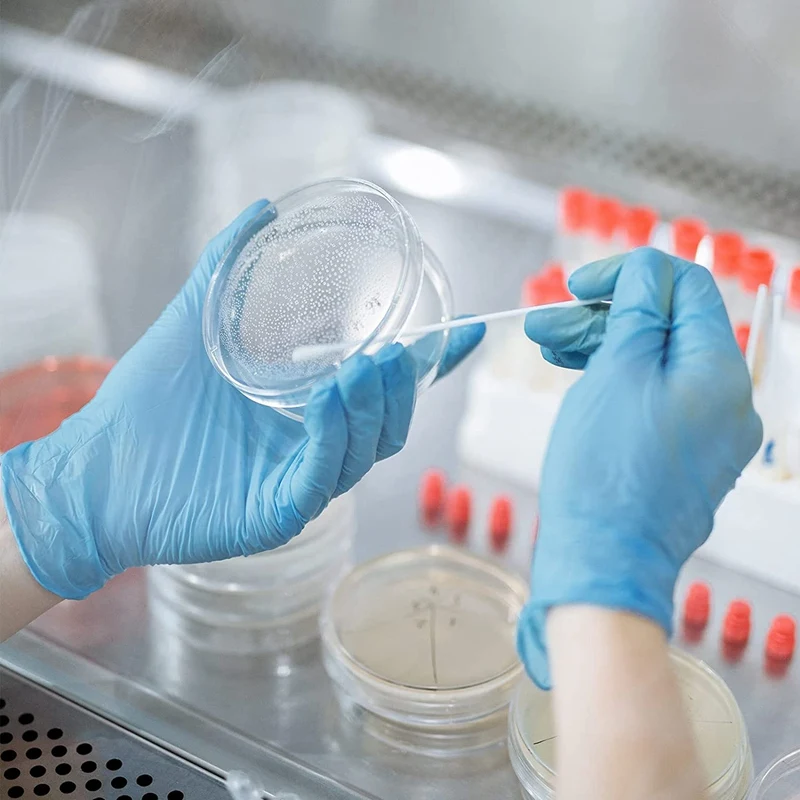
thumb

120 упаковок стерильных пластиковых чашек Петри с крышкой, прозрачные лабораторные чашечки Петри, чашечки для культивирования клеток
Customers also viewed

$4.93
Ультратонкий матовий магнітний бездротовий зарядний прозорий чохол для iPhone 16 15 14 Plus 13 12 Pro Max для Magsafe протиударний жорсткий чохол для ПК iPhone 13
joom.com
$33.60
smart watch male 1.85 555atm waterproof dwarfproof water heart rate monitor pedometer sport swimming smart watch male for
aliexpress.com
$11.75
Kenelephant Mouse Cheesecake Dolls Japan Genuine Candy Toy Model ANDY Figure Collection Ornaments Gashapon
aliexpress.com
$4.96
Repair Tool Multi-purpose High Quality Screwdriver Tool Set 32 Integrated Carbon Steel Hardware And Tools 32pcs Screwdriver Set
aliexpress.com
$9.99
2023 New In Summer 3D Men's T-shirt Set Sportswear Men's Oversized Clothing T-shirt Shorts Suit Men's T-shirt Tracksuit
aliexpress.com
$3.61
Bold Text Xmas Stamp Falling Stars Treelot Stencil DIY Scrapbooking Paper Craft Handmade Album Card Punch Embossing Template
aliexpress.com
$10.36
Ceramic European Style Cabinet Door Handle White Modern Minimalist Furniture Drawer Shoe Cabinet Cupboard Wardrobe Door Handles
aliexpress.com
$2.23
Creative Cute Little Devil Tissue Box Simple Multi-Functional Storage Paper Nordic Cartoon Tissue Box
aliexpress.com
$9.99
Dual Ends Metal Spudger Set for iPhone iPad Tablet Mobile Phone Prying Opening Repair Tool Kit Hand Tool Sets
aliexpress.com
$43.08
200kg door horizontal bars steel adjustable fitness training bar pull up arm training workout chin sit up bar push equipment
dhgate.com
$102.90
Свадебное платье ручной работы с инкрустацией стразами, инкрустированное цветочным рисунком, пианино для выступлений и приема, детское пла...
aliexpress.ru
$6.67
Luxury Air Humidifier Aroma Oil Humidificador USB Diffuser Quiet Cool Mist Sprayer For Bedroom Home Car Fragrance Purifier 130ML
aliexpress.com
$11.99
Доска для тхэквондо, доски для тренировок по разбиванию карате, деревянные доски для тренировок, искусства, штамповки, боевые деревянные Пр...
aliexpress.ru
$2.12
«Сделай сам», спиральные кухонные приборы из нержавеющей стали, женственная кухонная посуда, кухня, украшение для домашнего торта
aliexpress.ru
$12.58
Women Elegant Skirts 2022 VONDA Casual Solid Color Long Maxi Skirts A-Line Pleated Baggy Zipper Skirts Oversized
aliexpress.com
$13.07
Женская обувь, зимние женские ботинки, теплая плюшевая женская повседневная обувь на меху, модные кроссовки на шнуровке, женские зимние бот...
aliexpress.ru
$2.36
Hollow Thong Backless Jockstrap Briefs Men Sexy Breathable Underwear Erotic Underpants Thong Jocks Bikini Gay Mens Panties
aliexpress.com
$104.00
Nieuwe Ontwerp 904L Luxe Mens Ballon Horloge 33Mm 36Mm 42Mm Dial Automatische Mechanische Sapphire Rvs Blauw horloge
aliexpress.com
$0.01
Cosmetic Powder Puff Smooth Women's Makeup Foundation Sponge Beauty Make Up Blender Tools Accessories Water-Drop Shape
aliexpress.com
$12.66
Японская уличная одежда мужские черные бриджи с широкими штанинами, свободные спортивные повседневные спортивные брюки в стиле хип-хоп с э...
aliexpress.com
$44.59
farm shoes liberation shoes men's and women's military training shoes yellow sneaker military shoes high-top safety shoes work shoes camouflage shoes
fordeal.com
$163.21
waterproof camera backpack storage bag large/small 900d charging port tripod holder for dslr slr lens shutterbug outdoor travel
fordeal.com
$316.28
7420a078 крышка переднего колеса для pajero v97 5 дверей lhd колесная бровь для montero v95 v93 v98 серая окраска бесплатные клипы
dhgate.com
$42.05
2020 skateboard shoes men women platform sneakers dunk low utility black white volt red have a day flax mens trainer casual sports
dhgate.com
$5.50
Heart shaped sweet pink Morganite from Brazil AAAAAAAA quality with 7-12mm size ring surface faceted stone gems brilliant cut
aliexpress.com
$321.39
sweetheart mermaid wedding dresses with detachable train 2018 luxury lace beaded dubai arabic middle east princess castle wedding gown, White
dhgate.com